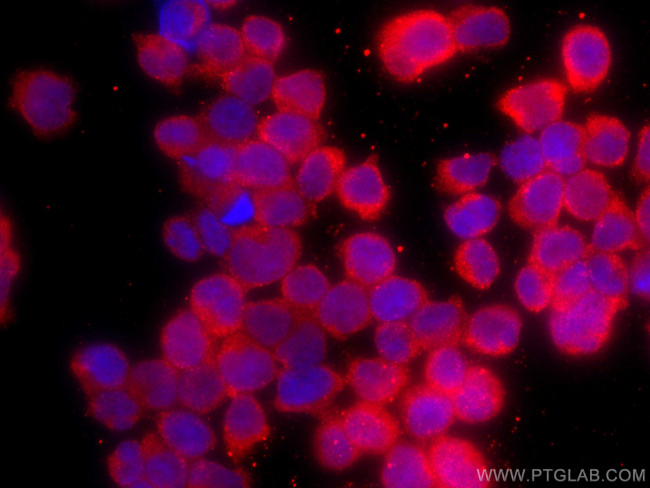
CDC25B Antibody in Immunocytochemistry (ICC/IF)

Search
Proteintech
CDC25B Monoclonal Antibody (1H3A4), CoraLite® 594
{{$productOrderCtrl.translations['antibody.pdp.commerceCard.promotion.promotions']}}
{{$productOrderCtrl.translations['antibody.pdp.commerceCard.promotion.viewpromo']}}
{{$productOrderCtrl.translations['antibody.pdp.commerceCard.promotion.promocode']}}: {{promo.promoCode}} {{promo.promoTitle}} {{promo.promoDescription}}. {{$productOrderCtrl.translations['antibody.pdp.commerceCard.promotion.learnmore']}}
产品信息
CL594-67145
种属反应
宿主/亚型
分类
类型
克隆号
抗原
偶联物
激发/发射光谱
形式
纯化类型
保存液
内含物
保存条件
运输条件
产品详细信息
Immunogen sequence: SQAPDGRRKS EAGSGAASSS GEDKENDGFV FKMPWKPTHP SSTHALAEWA SRREAFAQRP SSAPDLMCLS PDRKMEVEEL SPLALGRFSL TPAEGDTEED DGFVDILESD LKDDDAVPPG MESLISAPLV KTLEKEEEKD LVMYSKCQRL FRSPSMPCSV IRPILKRLER PQDRDTPVQN KRRRSVTPPE EQQEAEEPKA RVLRSKSLCH DEIENLLDSD HRELIGDYSK
靶标信息
Tyrosine protein phosphatase which functions as a dosage-dependent inducer of mitotic progression. Required for G2/M phases of the cell cycle progression and abscission during cytokinesis in a ECT2-dependent manner. Directly dephosphorylates CDK1 and stimulates its kinase activity. The three isoforms seem to have a different level of activity.
仅用于科研。不用于诊断过程。未经明确授权不得转售。
篇参考文献 (0)
生物信息学
蛋白别名: Dual specificity phosphatase Cdc25B; EC 3.1.3.48; M-phase inducer phosphatase 2; MPIP2
基因别名: AI604853; CDC25B; CDC25HU2; Cdc25m2
UniProt ID: (Human) P30305, (Mouse) P30306, (Rat) P48966
Entrez Gene ID: (Human) 994, (Mouse) 12531, (Rat) 171103